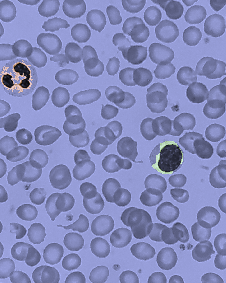
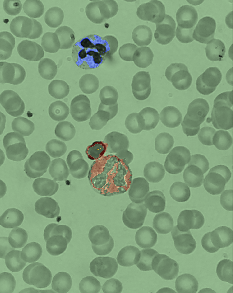
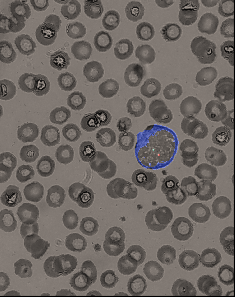

Our Awards & Recognition
Honorary Distinction – Innovation Center/University of Ioannina (May 2024)
Honored with a prestigious distinction for our innovative approach to AI-powered hematology diagnostics, recognizing our potential to transform healthcare delivery in Greece and beyond.
2nd Place Award – Beyond Tomorrow Start Up Competition – Athens (April 2025)
Awarded second place among innovative startups, highlighting our solution’s potential to address critical healthcare challenges through advanced technology.
2nd Place Award – Pfizer-Start 4Health Acceleration Lab – Thessaloniki (October 2024)
Secured second place in this competitive healthcare innovation program, validating our technology’s potential impact on medical diagnostics and patient care.
Selected Presenter – Greek Pediatric Hematology Oncology Conference – Athens (November 2024)
Selected to present our groundbreaking AI technology for blood cell analysis, demonstrating its practical applications in pediatric hematology.
Innovation Recognition – AI Visionaries- Leading Health Innovation – London (January 2025)
Our team member, Persefoni Perivolaropoulou, was recognized for her contribution to advancing AI applications in healthcare diagnostics.
Selected Member – Nvidia Inception Program
Proudly selected as a member of this elite program, gaining access to cutting-edge AI technology resources and expertise.
Selected Participant – StartSmart SEE Accelerator 2025 (March-June 2025)
Selected to participate in this prestigious Southeast European acceleration program, focusing on scaling our healthcare innovation.
Selected Participant – ConceptionX- Cohort 8 (March-July 2025)
Chosen to join this exclusive accelerator program, supporting our mission to revolutionize blood cell analysis through AI technology.
These recognitions reflect our commitment to advancing healthcare diagnostics and validate our innovative approach to addressing global healthcare challenges.
Blood Cell Processing
Upon obtaining a peripheral blood smear, the initial step involves the digital processing of the photograph to discern and segregate erythrocytes, leukocytes, and thrombocytes. The identification process is refined and accurate, owing to the advanced image analysis algorithms employed.
Following identification, individual erythrocytes are isolated through a cropping algorithm, allowing for targeted evaluation. The isolated erythrocytes are then analyzed by a sophisticated neural network trained to assess hematological parameters. This neural network classifies the red cells based on quantitative and qualitative criteria, such as size variance, hemoglobin concentration reflected in color, and morphological abnormalities.

Concurrently, leukocyte evaluation entails the use of a specialized algorithm to detect the nucleus within each white cell. The network has been trained to recognize and categorize the white cells into their respective classes: neutrophils, lymphocytes, monocytes, eosinophils, and basophils, based on nuclear morphology.
The analysis extends to the cytoplasm of each white cell, where the network categorizes the cells according to cytoplasmic staining and structure, ensuring a match between the identified nuclear type and its corresponding cytoplasmic characteristics.
Finally, the software identifies and enumerates thrombocytes within the visual field, providing a critical count of platelets. This platelet enumeration is essential for diagnosing thrombocytopenic or thrombocytotic states and guiding clinical intervention.
